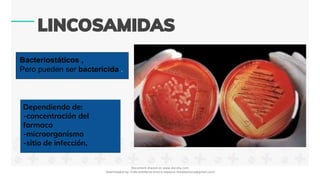
Bacteriostáticos ,
Pero pueden ser bactericida .
Dependiendo de:
-concentración del
farmaco
-microorganismo
-sitio de infección,
Document shared on www.docsity.com
Downloaded by: frida-estefania-orozco-esparza (freidaorozco@gmail.com)

Las lincosamidas son antibióticos que se unen a la subunidad 50S del ribosoma bacteriano e inhiben la síntesis de proteínas. La lincomicina fue sintetizada en 1962 y la clindamicina, un derivado más potente, fue desarrollada en 1966. Ambas tienen actividad contra bacterias grampositivas y algunas gramnegativas, y su mecanismo de acción implica la unión competitiva al sitio de acción de los macrólidos y el cloranfenicol en el ribosoma, impidiendo la unión del aminoacil-tRNA